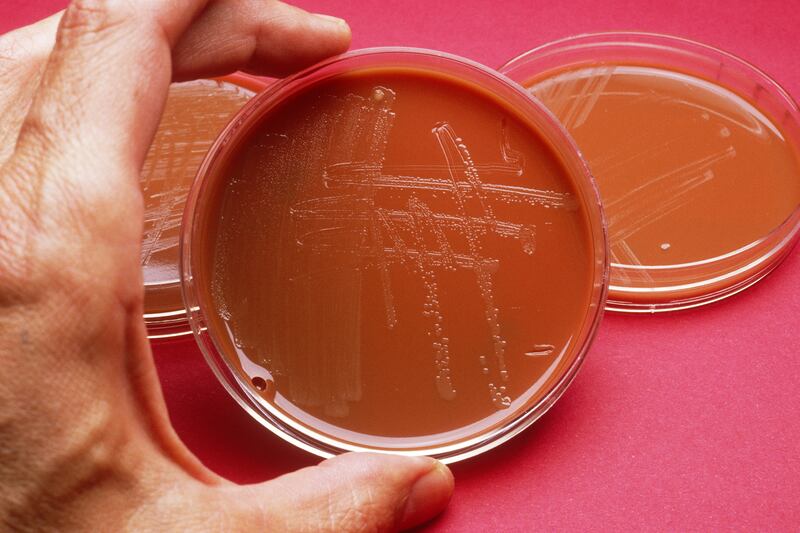
articles/2013/05/07/drug-resistant-gonorrhea-the-sex-superbug-is-not-worse-than-aids/130506-Sepkowitz-Gonorrhea-tease_kslmdw

It’s been a busy year for the world of infectious diseases. Close on the heels of carbapenemase-resistant Enterobacteriaceae, H7N9 avian flu in China, and SARS junior in Saudi Arabia are reports of highly drug-resistant gonorrhea in Hawaii. The strain, dubbed HO41 has landed just two years after first identification in Japan in 2011.
Even if doctors and the public health world are not quite prepared, the press certainly is. Ready and eager, too. CNBC and the Daily Mail, quick to the story, quoted a naturopathic doctor who suggested the new gonorrhea could be “a lot worse than AIDS in the short run because the bacteria is more aggressive and will affect more people quickly.” He went on to suggest that patients with gonorrhea can develop sepsis and die within a few days.
That’s not true. I have been practicing infectious disease since Bush 41 was president, and I have never seen a person die of gonorrhea. Yes, it is an extremely unpleasant and tragic infection that has led to infertility for thousands, perhaps millions of women, and yes, it occasionally though very rarely spills into the blood and can cause infection of the heart valve. But death is almost never on its menu. Oh, sure, of the 820,000 new gonorrhea infections occurring in the United States in 2008, I suspect one or two might have died of the disease. Although the $16 billion-a-year cost of gonorrhea and all the other STDs is frightening, the mortality of this particular bacterial infection is not.
Which is not to blame the doctor who gave the inflammatory quote to CNBC but rather to point out the perverse addiction the press seems to have for stories about superbugs. I have said my piece on the topic several times. But I also would like to bring the worried reader’s attention to a medical article on a related problem, the “superbug” called methicillin-resistant Staphylococcus aureus, or MRSA. Physicians, reporting with alarm on the problem in their hospital, wrote in the British Medical Journal, “At this stage it seemed possible that the majority of hospital staphylococcal infections might ultimately be caused by untreatable staphylococci.” The article came out in 1961 and was the first published report of MRSA. (Methicillin was called by its brand name, “Celbenin,” in the article.) The authors went on to finger the exact problem, writing that “it would be a tragedy to lose such a valuable new drug by lack of foresight.”
A tragedy indeed, but it is a tragedy that has played out again and again and will continue to play out. Antibiotics, as it turns out, are always hoist by their own petard. In the words of Dr. Richard Wenzel, a leader in the field of infectious diseases, “a predictive scenario [has] emerged: a novel antibiotic followed by the selection of resistant organisms and an urgent need for a still newer drug.” And what’s worse, the more potent the antibiotic, the more rapidly resistance may emerge. It’s a numbers game—the faster you kill off the susceptible bacteria, the more swiftly the few strains with natural resistance have the run of the place and can luxuriate in the available nutrients without competition.
This irony, that better drugs disappear faster, cannot be undone. It is, like death and taxes, a fact of life. And yet another fact of life—people like to have sex and always have and always will—makes this particular infection even more complex to control than others, such as TB or influenza. Anyone who doubts the latter axiom might consider that cases of gonorrhea in Utah (Utah!) rose 74 percent in 2012. There no longer is anywhere to hide from the swelter and welter of the American id.
The only surprising aspect of the current gonorrhea mini-story is the response from a group of medical leaders, the National Coalition of STD Directors. They recently marched up to Washington to demand some money. How much? $54 million. Now I don’t know much about this sort of thing, but that seems like chump change against a problem like drug-resistant gonorrhea. Plus, it implicitly overlooks the above facts. Perhaps for the lousy $54 million some scientist somewhere will twist a chemical structure or two and find a new antibiotic that works for this iteration of gonorrhea. But whatever $54 million antibiotic the bolus of cash might produce will itself become useless after a year or a decade. Gonorrhea will become resistant. It’s simple math.
We will not win the “war” against gonorrhea or any other resistant organism. The pathogens always will win, though we can feel good now and again having won a battle. The metaphors of war and crisis and sky-is-falling simply do not fit this particular struggle, try though the headlines may to turn this story too into a latter-day version of the USSR versus the USA or, more recently, the terrorists versus the freedom-lovers. What we are witnessing is not a battle for hearts and minds, for public opinion, or for a calming rationality to overtake the discussion. We are playing by the pathogens’ rules and simply don’t have a chance. Headlines won’t help any more than trivial amounts of money. It is a pity that public health authorities and drug manufacturers and everyone in between seem resistant to the truth.



